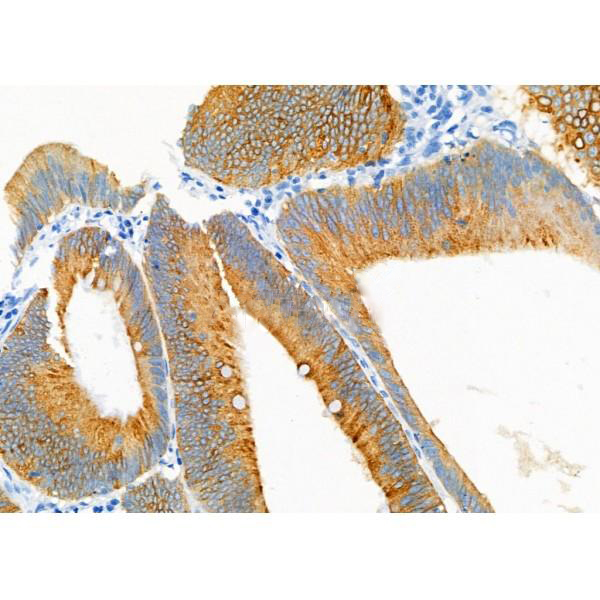

May play a role in postsynaptic function. The C-terminal gamma-secretase processed fragment, ALID1, activates transcription activation through APBB1 (Fe65) binding (By similarity). Couples to JIP signal transduction through C-terminal binding. May interact with cellular G-protein signaling pathways. Can regulate neurite outgrowth through binding to components of the extracellular matrix such as heparin and collagen I.
The gamma-CTF peptide, C30, is a potent enhancer of neuronal apoptosis.
Description
Rabbit polyclonal antibody to APLP1
Applications
WB, IHC.
Immunogen
APLP1 Antibody detects endogenous levels of total APLP1.
Reactivity
Human, Mouse, Rat.
可预测:Pig(100%), Bovine(%), Horse(%), Sheep(%), Dog(%)
Molecular weight
72kD; 72kD(Calculated).
Host species
Rabbit
Ig class
Immunogen-specific rabbit IgG
Purification
Antigen affinity purification
Full name
APLP1
Synonyms
AMYLOID BETA A4 PRECURSOR-LIKE PROTEIN 1; AMYLOID PRECURSOR-LIKE PROTEIN; Amyloid-like protein 1 precursor; APLP 1; APLP; APLP-1; Aplp1; APLP1_HUMAN; C30;
Storage
Rabbit IgG in phosphate buffered saline , pH 7.4, 150mM NaCl, 0.02% sodium azide and 50% glycerol. Store at -20 °C. Stable for 12 months from date of receipt.
Swissprot
P51693




 产品订购:
产品订购:
 渠道电话:
渠道电话: